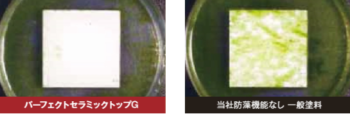

保存版 無機塗料を外壁や屋根に塗る その1 パーフェクトセラミックトップG
投稿日: 2019.1.20
ニッペ パーフェクトセラミックトップG

水性2液形セラミックハイブリット超高耐侯超低汚染無機系塗料
フッ素樹脂塗料を超える高耐侯性を発揮する、パーフェクトシリーズ史上最強の塗料です。

パーフェクトシリーズのラジカル制御技術を融合することで、フッ素樹脂塗料を超える高耐侯性を実現しました。
【セラミックハイブリット無機系塗料とは?】
無機塗料は紫外線に強く、高い光沢と不燃性が特長ですが塗膜の柔軟性を発揮しにくという性質がありました。
そこで無機の固い部分と有機の柔軟部分をハイブリット化することで「微弾性」の性能が発揮されます。
さらに表面に配向した無機系成分②により、超低汚染性を実現します。


無機塗料は紫外線に強く、チョーキング(手に白い粉がつく現象)が起きにくいです。
無機の成分を主体に有機物を混ぜ作ってありますが、無機自体は石やガラスの様な長持ちする物質です。
高耐侯性酸化チタンと光安定剤によるW効果で、耐侯性を高める「ラジカル制御」技術により、紫外線に強い強靭な塗膜を形成し、塗り立ての美しさを長期間保ちます。
外壁塗装で塗膜が劣化してしまう原因として紫外線が酸化チタンを吸収するとラジカルが発生しあらゆる物質を分解してしまいます。塗膜も分解されてしまうため、劣化し、チョーキングなどの現象を起こしてしまいます。パーフェクトトップはこのラジカルを発生させないようダブルの仕組みを備えています。


パーフェクトセラミックトップGは、専用中塗りと上塗りの高いレベリング性により、つやが優れています。
レベリング性とは塗膜が均一に平らになることを示す度合いです。
ポリマーが塗膜間の隙間を埋めるため、緻密な塗膜形成が可能となり、優れた高光沢を実現できました。

塗膜は親水性によって、建物外観に付着した汚れを洗い流し、美観を維持することができます。
雨が降ると外壁表面の掃除をしてくれます。


無機の特性を活かし、燃焼実験において優れた難燃性を有しています。


藻・かびの発生を抑制し、建物の美観と清潔な環境をまもります。

透湿性があるため塗膜の膨れや剥離を抑制することが可能です。
ニッペ パーフェクトシリーズの比較表です。

以上、保存版 無機塗料を外壁や屋根に塗る その1でした。
徳島で無機塗料の事ならお任せください!













